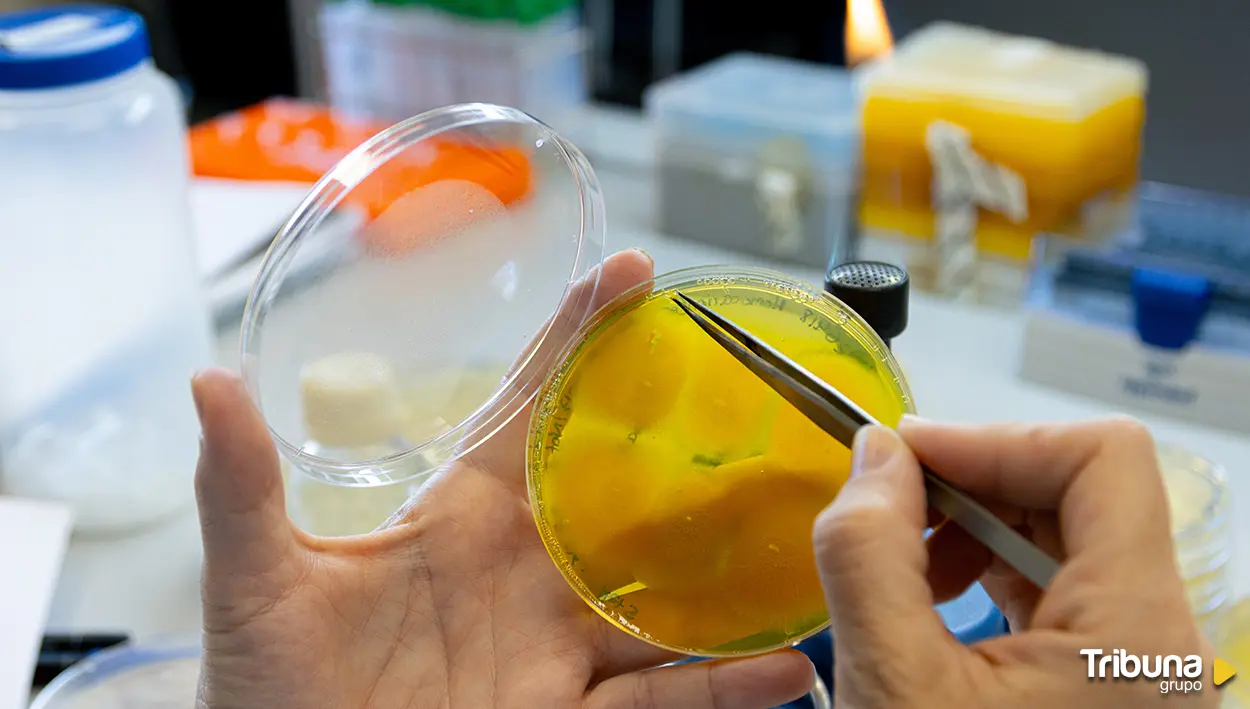

'RareBioTech' y 'Legalinnova' reciben 4.000 euros cada una y el pase a la gran final nacional del galardón de emprendimiento universitario
El hongo que transforma basura en vitaminas y aromas naturales : la apuesta sostenible de la USAL
Investigadores de la Universidad de Salamanca han convertido residuos como aceite usado en compuestos útiles para la industria gracias a la biotecnología
Transformar lo que normalmente se desecha, como restos de poda, cáscaras de frutas o aceite de cocina usado, en productos útiles y sostenibles ya no es una idea futurista, sino una realidad científica. En plena transición hacia una economía circular, investigadores de la Universidad de Salamanca han logrado avances significativos para revalorizar residuos orgánicos mediante biotecnología.
Desde el Grupo de Investigación Reconocido en Ingeniería Metabólica, un equipo multidisciplinar ha convertido al hongo filamentoso Ashbya gossypii en una biofábrica capaz de transformar desechos agroindustriales y domésticos en compuestos valiosos para la industria alimentaria, farmacéutica y cosmética. "El objetivo es aprovechar su capacidad metabólica única para convertir residuos orgánicos en productos de alto valor añadido, tales como suplementos nutricionales, compuestos bioactivos y precursores industriales", explica Rubén Martínez, director del GIR.
Gracias a técnicas de modificación genética y edición genómica como CRISPR/Cas9, los científicos han conseguido redirigir el metabolismo del hongo. Según Alberto Jiménez, catedrático del Área de Genética, "hemos conseguido convertir desechos agrícolas y domésticos, como el aceite de cocina que habitualmente utilizamos en los hogares, en aromas naturales y vitaminas esenciales, contribuyendo al cuidado del medio ambiente y al impulso de la economía circular".
Uno de los avances más notables ha sido publicado en Fungal Biology and Biotechnology bajo el título 'Ashbya gossypii as a versatile platform to produce sabinene from agro‑industrial wastes'. En este estudio, el hongo fue modificado genéticamente para producir compuestos aromáticos como sabineno y limoneno, presentes en perfumes, cosméticos o productos de limpieza con olor a limón o pino.
Para ello, los investigadores integraron genes de plantas y reconstruyeron rutas biosintéticas propias de especies vegetales. "Tenemos que integrar genes de plantas y trasladar rutas biosintéticas de plantas en el hongo para aportarle esta nueva actividad, tenemos que modificar esas enzimas para que funcionen de manera óptima en A. gossypii", señala Martínez.
Una vez modificadas las cepas, se cultivaron con residuos agrícolas como mazorcas de maíz o melazas de caña de azúcar. El resultado fue una producción eficiente y sostenible de los compuestos. "Podemos decir que obtenemos niveles de producción comparables con otras factorías microbianas, con otros microorganismos situados en el top de la producción de compuestos a nivel microbiológico", afirma el director del grupo.
VALOR AÑADIDO AL ACEITE USADO
El segundo estudio, publicado en New Biotechnology y titulado 'Valorization of waste cooking oil for bioproduction of industrially-relevant metabolites in Ashbya gossypii', presenta otra hazaña científica: transformar aceite de cocina usado en vitamina B2 (riboflavina), vitamina B9 (ácido fólico) y aceites microbianos útiles.
"El hongo actúa como una biofábrica, convirtiendo basura orgánica en una sustancia de gran valor. Es una triple solución: ambiental, de salud y económica", destacan los investigadores. Se trata del primer proyecto con A. gossypii que emplea este tipo de residuo y demuestra su capacidad para generar compuestos de alto valor de forma simultánea.
Este enfoque no solo produce vitaminas esenciales para la salud humana y animal, sino que reutiliza un residuo altamente contaminante y de difícil gestión. "Aporta valor a un residuo que todos generamos, el aceite de cocina, que es un desecho que daña de manera importante al medioambiente y que puede suponer un riesgo para la salud", aclaran.
Ambos proyectos muestran cómo la combinación de ingeniería genética avanzada y aprovechamiento de residuos agroindustriales puede dar lugar a soluciones integrales alineadas con los principios de la bioeconomía. "Producimos compuestos de interés biotecnológico como vitaminas o algunas grasas especializadas a partir de desechos domésticos o agroindustriales", resume el equipo.
Rubén Martínez lo deja claro: "El contexto de los dos proyectos es directamente la bioeconomía, la economía circular, la transición ecológica. Intentamos producir ahora de forma más rápida y conveniente lo que antes obteníamos de una manera más perjudicial para el medioambiente y más costosa económicamente", ha asegurado.
Además, el enfoque tiene un fuerte potencial para el desarrollo rural. En regiones como Castilla y León, donde se generan grandes cantidades de residuos agrícolas, estas tecnologías podrían convertirse en una fuente de valor local, fomentando la creación de empleo y el aprovechamiento descentralizado de recursos.
"En lugar de incinerar o enterrar toneladas de restos agrícolas y domésticos, demostramos cómo estos pueden convertirse en ingredientes para productos que usamos a diario", concluyen los investigadores.
La iniciativa combina el trabajo científico de jóvenes con discapacidad con visitas de campo a Atapuerca y el Museo de la Evolución Humana
El rector ha inaugurado en el Paraninfo una edición marcada por el liderazgo de alumnos de Estados Unidos y el fuerte crecimiento del mercado chino y alemán
El equipo ha descubierto en Segovia una escultura en mármol que podría representar al mandatario romano, del que apenas hay 21 retratos en el mundo








